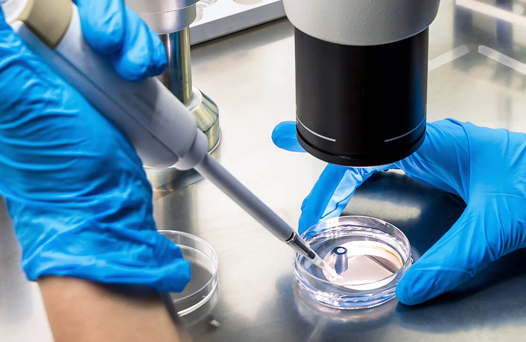

COMPETENCE AND PROFESSIONALISM
Our laboratories located in Delhi are equipped with high-tech instruments, enabling us to work using the most innovative technologies available. Consequently, we offer a broad spectrum of pharmaceuticals in every dosage form, including injectables, inhalers, tablets, capsules, and liquids.
Thanks to meticulous examinations of every batch and long-time cooperation with authorized suppliers, we guarantee the highest quality of our products, which was repeatedly proved in third-party tests.
Our team understands the importance of evaluating topical excipients and the impact of material characteristics on the final product. We have developed first-rate testing protocols, thus minimizing the risk of variation in the concentration of the active substance by different batches and guaranteeing maximum safety. Our top-grade products meet the most demanding technical requirements for pharmaceutical and nutrition products in the USA and Europe.